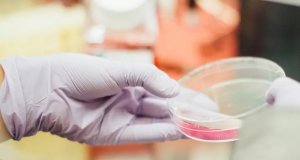
Avanza Rusia en desarrollo de vacuna contra COVID-19

Aplazan Juegos Olímpicos de Tokio 2020
Los Juegos Olímpicos de Tokio 2020 se aplazan debido a la pandemia del nuevo coronavirus. El Comité Olímpico Internacional (COI) anunció que se realizarán...
Avanza Rusia en desarrollo de vacuna contra COVID-19
Las autoridades sanitarias de Rusia anunciaron este lunes que la vacuna contra el COVID-19 superó la primera fase de pruebas y ésta podría estar...
Aprueban en EE.UU. test para detectar COVID-19 en 45 minutos
La Administración de Alimentos y Medicamentos de Estados Unidos (FDA por sus siglas en inglés) aprobó la primera prueba rápida de coronavirus (COVID-19), que...
OMS resuelve dudas de COVID-19 vía WhatsApp
Ante el actual brote por coronavirus (COVID-19) que fue notificado por primera vez en Wuhan, China el pasado diciembre de 2019, la OMS lanzó un servicio...
Frontera de México y EU no se cierra, pero sí restringen...
El Gobierno del presidente de Estados Unidos, Donald Trump, anunció este viernes un acuerdo con México para "la suspensión del tráfico no esencial" de...
Por infidelidad todo un pueblo está en cuarentena en Selva, Argentina
Un posible caso de contagio de coronavirus puso en cuarentena a todo un pueblo en Argentina, los habitantes esperan los resultados de los análisis
Una...
Se queda “chiquito” el apoyo económico en México para COVID-19
Gobierno federal adelanta que destinará sólo 3 mil 500 mdp
Mientras el gobierno de México anunció que destinará casi 3 mil 500 millones de pesos...
Ibuprofeno empeora coronavirus; OMS pide no combatir el Covid-19 con este...
La hipótesis que una enzima que estimula el ibuprofeno y otros medicamentos similares podría facilitar y empeorar las infecciones por el virus.
La Organización Mundial...
Arrancan primeras pruebas en humanos de la vacuna contra el Covid-19...
Los Institutos Nacionales de la Salud de EE.UU. (NIH, por sus siglas en inglés) han anunciado el inicio de la primera fase de ensayo...
Esposa del Presidente de España da positivo en Covid-19
Begoña Gómez, esposa del presidente del Gobierno, Pedro Sánchez, ha dado positivo en el test de coronavirus que le han practicado en las últimas...